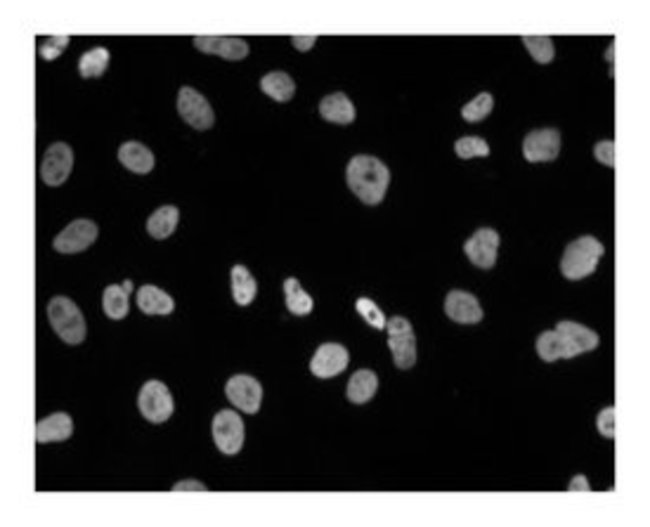

54nrb Mouse, Unlabeled, Clone: 3, Bd, Mouse Monoclonal Antibody, Each
|
|
Details:
Splicing, the removal of introns from pre-mRNA, is mediated by spliceosomal complexes that contain multiple snRNPs and a number of non-snRNP splicing factors, such as hPRP17 and hPRP18. p54 [nrb] ( n uclear R NA- b inding kDa) is a non-snRNP RNA splicing factor. It binds and enhances the activity of topoisomerase I, the enzyme that nicks DNA to relieve torsional stress during replication and transcription. p54 [nrb] is the the human homolog of mouse NonO and bovine IPEB. The N-terminal half of p54 [nrb] contains two RNA recognition motifs (RRMs), that allow it to bind single stranded RNA. These motifs are included in a region that is 71% homologous with the human splicing factor PSF and 42% homologous with the Drosophila puff-specific protein BJ6. In addition to its role in RNA splicing, p54 [nrb] functions as a DNA transcription factor in multiple cell types. The N-terminal portion of p54 [nrb] also mediates its interaction with DNA. The ability of p54 [nrb] to bind DNA, but not RNA, is thought to require post-translational modification. Thus, p54 [nrb] can function as either an RNA splicing factor or a DNA transcription factor in a post-translational-dependent manner.
Additional Information
| SKU | 10135331 |
|---|---|
| UOM | Each |
| UNSPSC | 12352203 |
| Manufacturer Part Number | 611279 |
